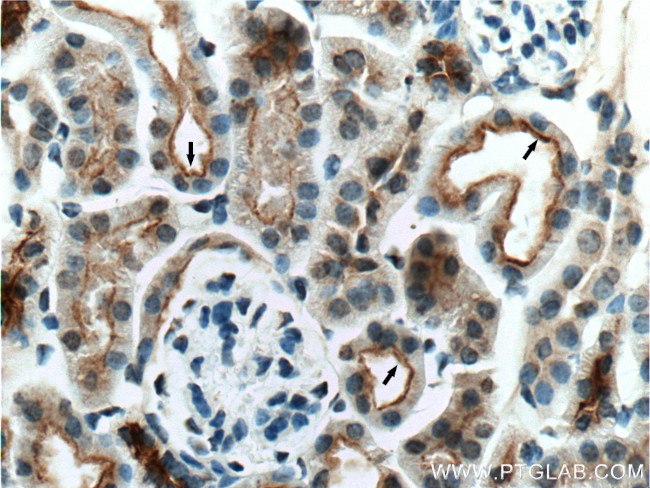
NHE3 Antibody in Immunohistochemistry (Paraffin) (IHC (P))

Search
Proteintech
NHE3 Polyclonal Antibody
{{$productOrderCtrl.translations['antibody.pdp.commerceCard.promotion.promotions']}}
{{$productOrderCtrl.translations['antibody.pdp.commerceCard.promotion.viewpromo']}}
{{$productOrderCtrl.translations['antibody.pdp.commerceCard.promotion.promocode']}}: {{promo.promoCode}} {{promo.promoTitle}} {{promo.promoDescription}}. {{$productOrderCtrl.translations['antibody.pdp.commerceCard.promotion.learnmore']}}
产品信息
27190-1-AP
种属反应
宿主/亚型
分类
类型
抗原
偶联物
形式
浓度
规格
纯化类型
保存液
内含物
保存条件
运输条件
产品详细信息
Immunogen sequence: KSTKLGLNQ NKKAAKLYKR ERAQKRRNSS IPNGKLPMES PAQNFTIKEK DLELSDTEEP PNYDEEMSGG IEFLASVTKD TASDSPAGID NPVFSPDEAL DRSLLARLPP WLSPGETVVP SQRARTQIPY SPGTFRRLMP FRLSSKSVDS FLQADGPEER PPAALPESTH M (665-834 aa encoded by BC101669)
靶标信息
NHE3 (also known as SLC9A3 - Sodium/hydrogen exchanger 3) is a member of the sodium/hydrogen exchanger family that plays a crucial role in acid-base and volume homeostasis by mediating the majority of sodium and bicarbonate reabsorption in the proximal tubule of the kidney. Mutations in the gene can lead to Diarrhea 8.
仅用于科研。不用于诊断过程。未经明确授权不得转售。
生物信息学
蛋白别名: MGC126718; MGC126720; Na(+)/H(+) exchanger 3; NHE-3; NHE-3 antibody; SLC9A3 antibody; Sodium/hydrogen exchanger 3; solute carrier family 9 (sodium/hydrogen exchanger), member 3; Solute carrier family 9 member 3; solute carrier family 9, subfamily A (NHE3, cation proton antiporter 3), member 3
基因别名: 9030624O13Rik; AI930210; DIAR8; NHE-3; NHE3; SLC9A3
UniProt ID: (Human) P48764, (Mouse) G3X939
Entrez Gene ID: (Human) 6550, (Mouse) 105243